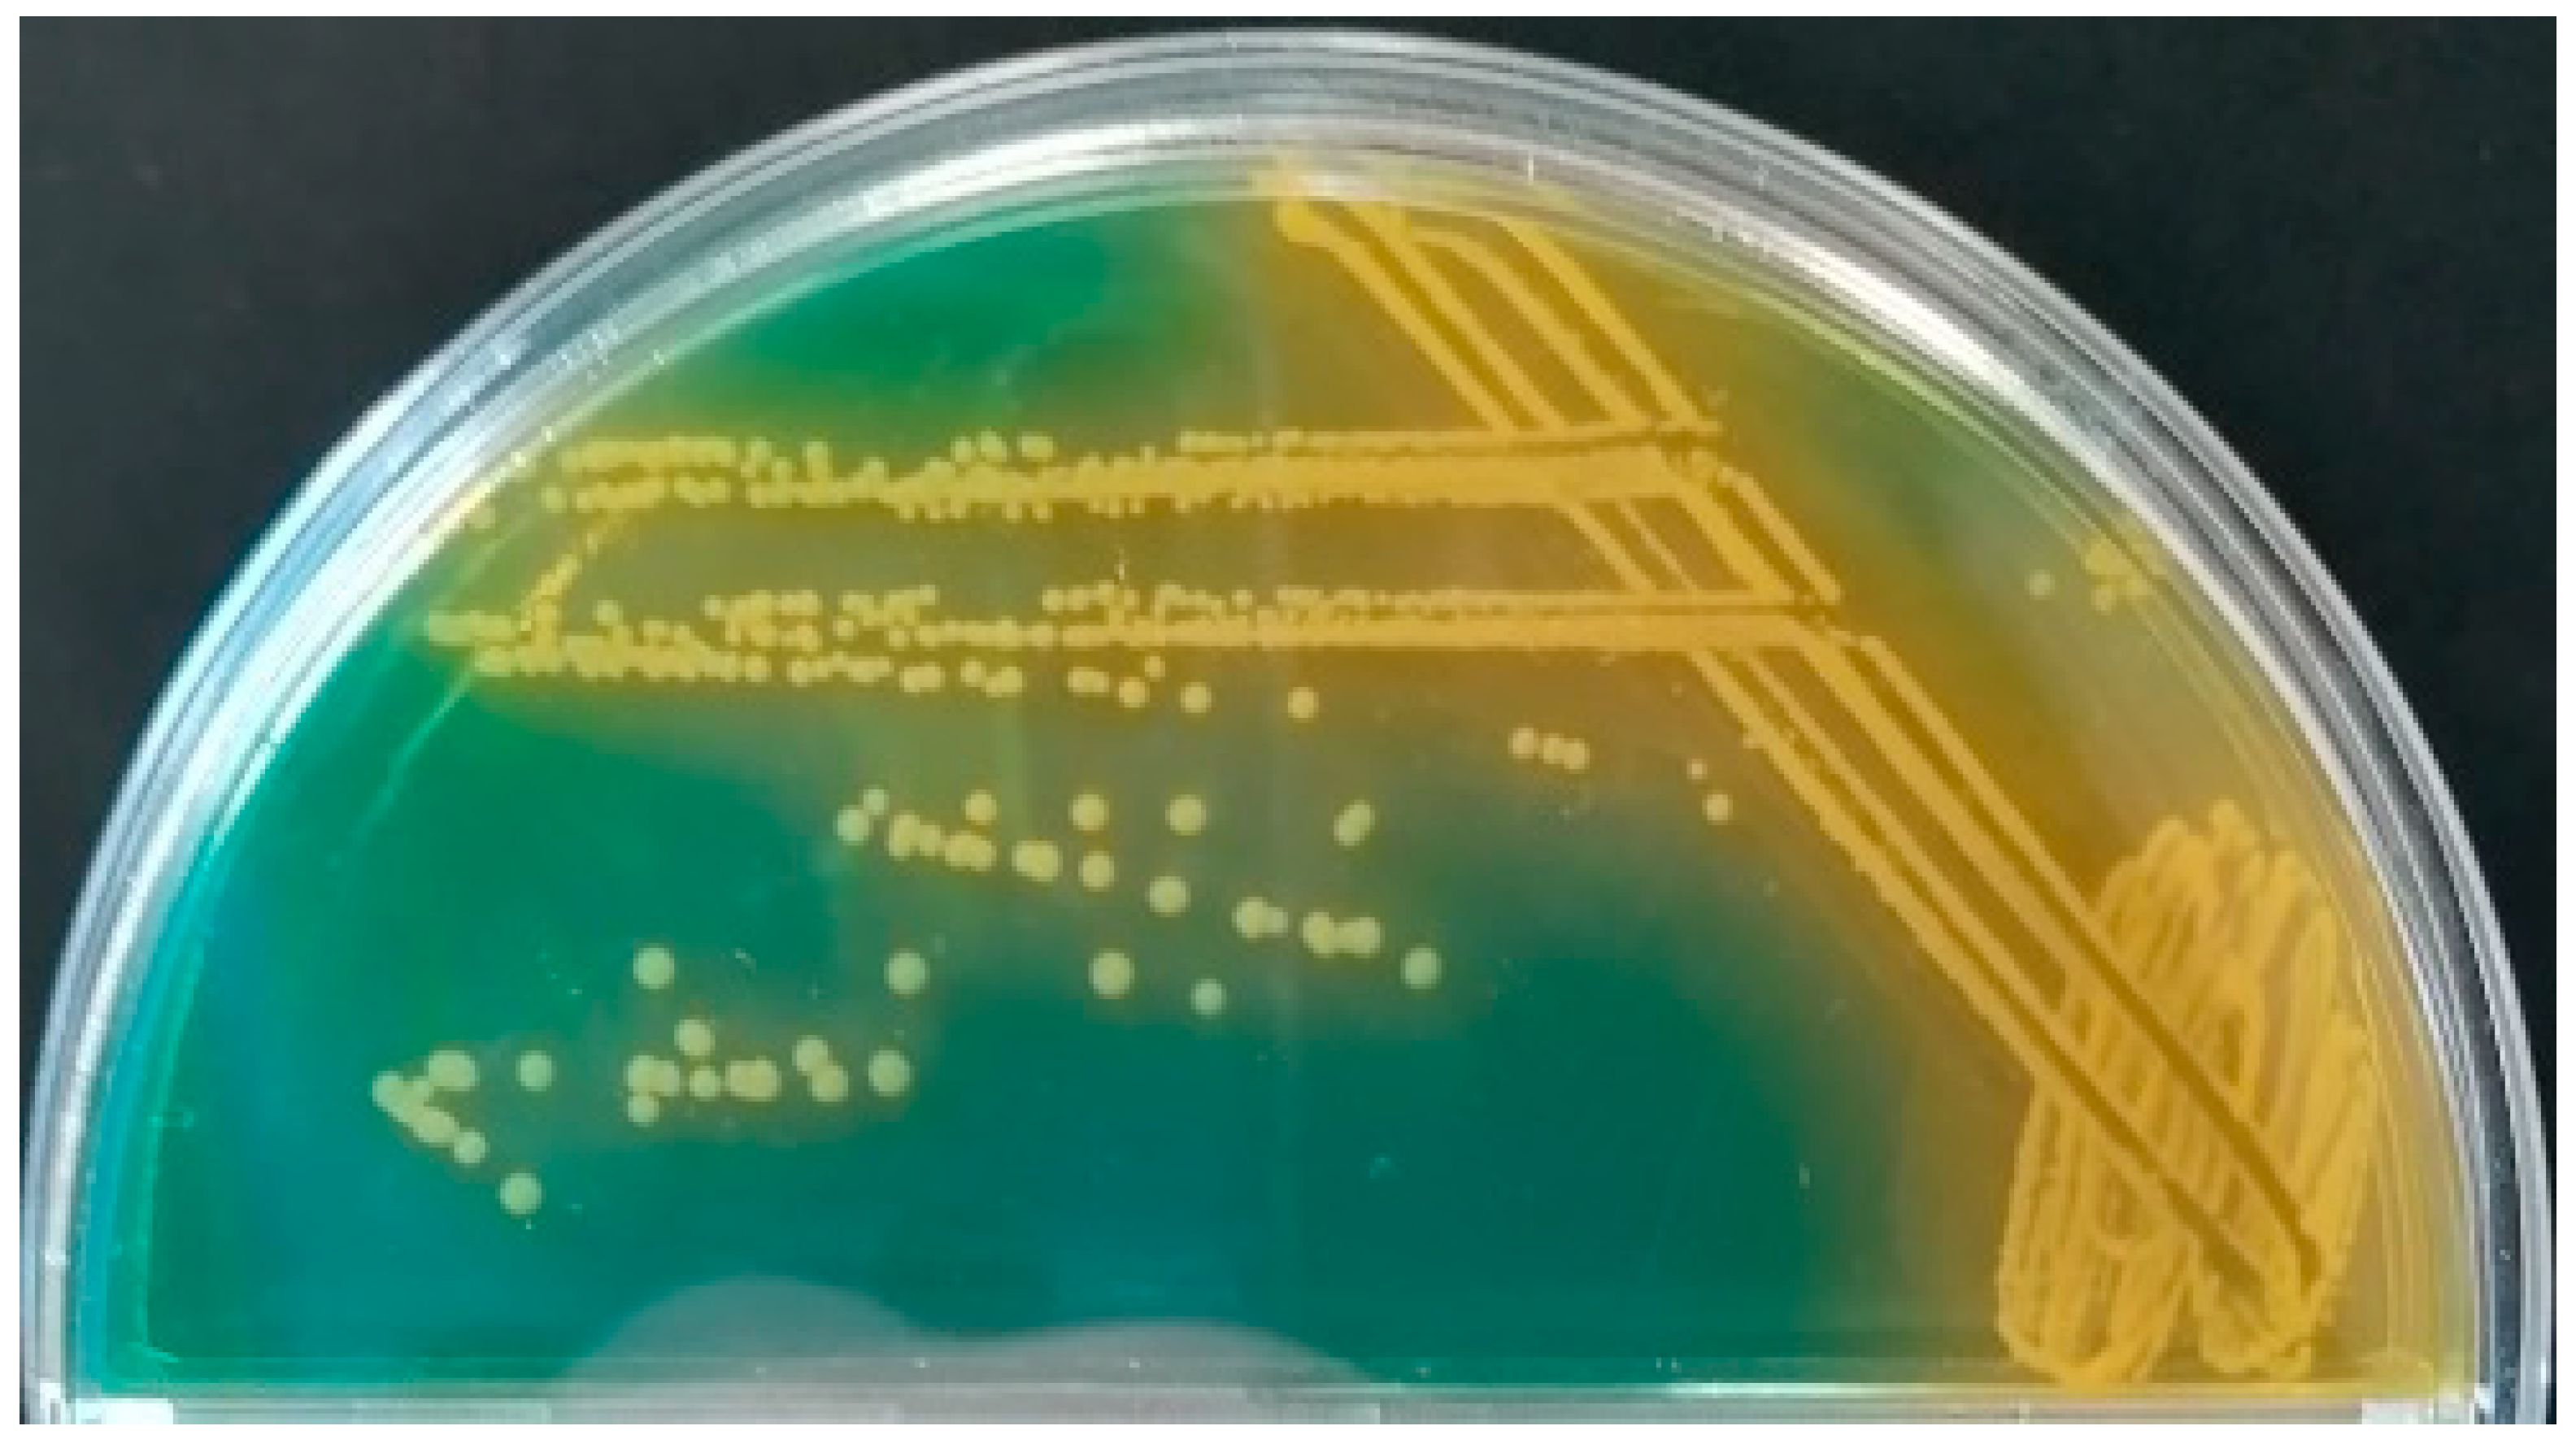
Microorganisms 09 00922 g002

Abstract
Pinna nobilis populations, constituting the largest bivalve mollusk endemic to the Mediterranean, is characterized as critically endangered, threatened by extinction. Among the various factors proposed as etiological agents are the Haplosporidium pinnae and Mycobacterium sp. parasites. Nevertheless, devastation of the fan mussel populations is still far from clear. The current work is undertaken under a broader study aiming to evaluate the health status of Pinna nobilis population in Aegean Sea, after the mass mortalities that occurred in 2019. A significant objective was also (a) the investigation of the etiological agents of small-scale winter mortalities in the remaining populations after the devastating results of Haplosporidium pinnae and Mycobacterium sp. infections, as well as (b) the examination of the susceptibility of the identified bacterial strains in antibiotics for future laboratory experiments. Microbiological assays were used in order to detect the presence of potential bacterial pathogens in moribund animals in combination with molecular tools for their identification. Our results provide evidence that Vibrio bacterial species are directly implicated in the winter mortalities, particularly in cases where the haplosporidian parasite was absent. Additionally, this is the first report of Vibrio mediterranei and V. splendidus hosted by any bivalve on the Greek coastline.
1. Introduction
Marine habitats constitute natural hosts for a plethora of microorganism communities, which play key roles in fundamental functions among each ecosystem [1]. Microbes are often engaged in a mutualistic symbiosis with many inhabitants in marine environments, assisting them in mechanisms such as immune functions, physiological responses in various factors, and nutrient uptake [2,3,4]. Apart from the beneficial properties sometimes offered to the hosts, microbes can also act pathogenically under certain conditions and may become opportunistic, leading to disease pathogenesis [5]. Stressful conditions as a result of climate change can have a negative impact on the physiological responses of hosts, as well as implicating with lower immune responses [6,7]. At the same time, an increase in the average temperature can favor the colonization of bacterial genera such as Vibrio spp., inducing their virulence factors [8]. However, parasitism can expose the host species to secondary infections, which, together with the main causative agent, can increase the pathogenicity at the expense of the host [9,10].
Mortalities in Pinna nobilis populations persist in threatening the species towards extinction. This phenomenon started on the Spanish coastline in 2016 (Alicante, Spain), reaching mortalities at a ratio of 100%, infecting P. nobilis populations in all life stages, and was directly associated with the presence of a new emerging Haplosporidan parasite [11,12]. Morphological and molecular characterization were performed one year later alongside phylogenetic analysis, which confirmed the taxonomic status of the newly emerged parasite in the order Haplosporida [13]. Mortalities are still spreading in the Mediterranean Sea populations of P. nobilis, with the addition of a new potential candidate causative agent of mortalities. Mycobacterium species were detected alongside H. pinnae in the Tyrrhenian Sea (Mediterranean) in moribund individuals of P. nobilis, causing strongly inflammatory lesions, and were proposed as a new potential threat for the populations of fan mussels [14]. Meanwhile, the detection of H. pinnae persisted in mortalities in the Ionian and Aegean Sea, having a great negative impact on populations of fan mussels and causing the change of the ranking of the species in the Mediterranean Sea to Critically Endangered according to the IUCN red list [15,16,17,18,19,20,21]. Both aforementioned pathogens have been detected in P. nobilis populations suffering from mortalities on Croatian coastlines, thus invading the last safe shelter of the species from the mortalities that occurred in the rest of Mediterranean Sea [22,23]. The only parasite-free area is the Sea of Marmara, which was recently referred as unaffected from the epidemic [24]. Apart from the presence of the pathogens mentioned before, new potential pathogens were detected for the fan mussel in a survey conducted in Italy (Campania, Tuscany, Sardinia, and Apulia) and Spain (Catalunya). The presence of Vibrio spp. and Perkinsus sp. alongside mycobacteria and H. pinnae have been suggested to represent a harmful combination in disease pathogenesis against the fan mussel populations [25]. In a rescue project for P. nobilis conducted in Catalunya, a new pathogen emerged in individuals free from the parasites mentioned above. V. mediterranei was detected in dead individuals when the temperature rose between April and May (17–19 °C) in stable animals, and was later demonstrated to be infectious with the presence of specific virulence genes [26,27]. In the context of exploration in the P. nobilis microbiome, identification of eight different bacterial taxa was performed and the results concluded the presence of V. splendidus clade bacteria [28]. The multifactorial attributed mortality scenario was strengthened by a molecular survey conducted in Italy, which demonstrated that H. pinnae is not species-specific, but had occurred in marine bivalves since 2014, thus challenging the finding that H. pinnae is the unique etiological agent of the mortalities of P. nobilis in Mediterranean Sea [29]. In a recent study, investigating the biochemical performance of the species, specimens collected before and after the mortality events were compared, and the results provided evidence that Mycobacterium sp. existed in the species long time ago before mortalities occurred [30]. The theory of a pathogenic cluster of agents, which causes mortalities, was also supported in a study conducted using, for the first time, the powerful tool of next-generation sequencing of the 16s-rRNA gene in P. nobilis individuals. The microbiome of individuals from three different populations, previously described to be infected from H. pinnae and Mycobacterium sp. [17], were analyzed, and revealed the presence of 14 different bacterial OTUs, among which were bacterial genera such as Vibrio sp., Mycoplasma spp., Pseudoalteromonas spp., Mycobacterium sp., Aliivibrio spp., Photobacterium spp., and Psychrilyobacter spp. [31]. The aforementioned genera can be symbiotic or pathogenic genera for bivalves, supporting the complexity of mass mortality events. However, even before the onset of mortalities with pathogenic microorganisms as causative agents, the P. nobilis population along the Mediterranean Sea faced human pressure, which resulted in a serious decline in the population in the last few decades. Illegal fishing for seafood or decorative purposes, anchoring, bycatches, and habitat destruction have pushed the populations towards their lower survival limits [32,33].
In the context of continuous mortalities in Greece, the current study was conducted in order to assess the status of the remaining P. nobilis populations in Greek territory. After the collapse of fan mussel populations in Thermaikos gulf, Thessaloniki [19], the remaining populations with the highest density, which were chosen for investigation, were the populations in Kalloni gulf, Lesvos Island and Maliakos gulf, Fthiotis (Figure 1). The main objectives of this study were (a) the monitoring of the two remaining populations in Greece regarding haplosporidian and mycobacteria parasites during the winter months; (b) identification of other harmful bacteria such as Vibrio spp. that have been detected by P. nobilis microbiome analysis; (c) investigation of small-scale mortalities in the aforementioned gulfs; and, furthermore, (d) to determine the most effective antibiotics that could possess antimicrobial activity against the newly identified Vibrio species. Taken altogether, the study aims to enlighten and contribute to the determination of the etiological agents of the fan mussel P. nobilis mortalities.

Figure 1.
Sampling sites of P. nobilis specimens from Kalloni gulf, Lesvos Island (39.095818, 26.149199) and Maliakos gulf, Fthiotis (38.805781, 22.613020), within the Aegean Sea.
2. Materials and Methods
2.1. Sampling
In order to evaluate the status of the remaining P. nobilis in the last refugia in Greece, samplings of P. nobilis specimens were performed in 2 different marine areas in the Aegean Sea, i.e., Kalloni gulf, Lesvos island and Maliakos gulf, Fthiotis during February 2020 and April 2020 (Figure 1). Thirty moribund samples were collected in 2020. Ten samples originated from Kalloni gulf, Lesvos island, divided in two sampling efforts with equal samples each, and the other twenty were from Maliakos gulf, Fthiotis, divided into ten samples in each sampling effort.
All samplings were carried out in compliance with the terms of a particular license received from the Greek Ministry of Environment and Energy (code: MEE//GDDDP89926/1117). P. nobilis specimens were dissected immediately after collection in aseptic conditions. Each tissue was divided in small parts and each part was placed in sterilized 1.5ml tubes and stored in liquid nitrogen for further analyses. Additionally, a small part of the digestive gland was kept and fixed for histological process.
2.2. Histological Procedure
Histopathological examination of the samples was performed exactly as described in Lattos et al. [17] in an effort to evaluate the pathological condition of the tissues, as well as the potential differences in infections caused by different microorganisms.
2.3. Microbiological Methods
2.3.1. Culture Media
Tryptic soy agar (TSA, Oxoid) was used as the nonselective media, and thiosulfate citrate bile salts sucrose (TCBS, Oxoid) for the isolation of Vibrio strains. They were both prepared according to the manufacturer’s instructions, with the addition of 2% NaCl (Oxoid). Additionally, tryptic soy broth (TSB, Oxoid) with 2% NaCl was used for the cryopreservation of the strains at −80 °C in a final dilution of 15% glycerol.
2.3.2. Bacterial Isolation
One gr of the different pen shell tissues (mantle, gill, digestive gland, and muscle) were homogenized with 9 mL of sterile PBS buffer [26]. 100 μL of homogenate was used to inoculate on TSA and TCBS agar supplemented with 2% NaCl. The plates were incubated for 24–48 h at 25 °C and observed for bacterial growth. For isolation, single colonies were picked and stroked onto new plates (Figure 2). Liquid cultures were incubated overnight at 25 °C. All isolates that were used for further identification and analysis were the ones found dominant in the first step of inoculation on TSA and TCBS.

Figure 2.
Subculture of a single colony on TCBS with 2% NaCl.
2.3.3. Antibiogram
The susceptibility of Vibrio species to various antimicrobials was determined through the disk diffusion method, according to the guidelines of the Clinical and Laboratory Standards Institute [34]. The antibiograms in all strains isolated and identified were prepared using 15 antibiotic disks: florfenicol (FFC, 30 μg), erythromycin (E, 15 μg), cephalothin (KF, 30 μg), cefotaxime (CTX, 30 μg), ampicillin (AMP, 10 μg), amoxicillin/clavulonate (AMC, 20 μg and 10 μg, respectively), kanamycin (K, 30 μg), neomycin (N, 30 μg), gentamycin (GM, 10 μg), streptomycin (S, 10 μg), trimethoprim sulfamethoxazole (SXT, 1.25 μg and 23.75 μg, respectively), ciprofloxacin (CIP, 5 μg), flumequine (UB, 30 μg), norfloxacin (NOR, 10 μg), and tetracycline (TE, 30 μg).
The bacterial strains were inoculated into Mueller–Hinton broth (Oxoid) containing 2% NaCl and incubated overnight at 25 °C. Afterwards, each suspension was adjusted to the turbidity of a 0.5 McFarland standard and spread onto Mueller–Hinton agar (Oxoid) plates containing 2% NaCl. The antibiotic disks were placed on the plates that were then incubated for 24 h at 25 °C. The diameter of the inhibition zone around each disk was measured and recorded. The results were classified as resistant (R), intermediately resistant (I), or susceptible (S) according to the CLSI guidelines [34].
2.4. Molecular Identification of Pathogens
Pure cultures of bacteria stored at −80 °C were incubated onto TSB with 2% NaCl for 24–48 h for the extraction of DNA. DNA extraction was conducted using the DNAEasy Blood and Tissue kit (QIAGEN, Germany) according to the manufacturer’s instructions. The quality and quantity of the isolated DNA was evaluated spectrophotometrically in a NanoDrop (Shimadzu, Japan). Approximately 50 ng of extracted DNA were subjected in a 20 μL volume PCR using 10 μL of the FastGene Taq 2x Ready Mix (NIPPON Genetics, Europe) and 0.6 pmol of each one of the primers 27f-CM and 1492r modified by Frank et al. [35] that amplify a c. 1200 part of the 16Sr RNA gene in bacteria. The following PCR conditions were applied: initially, a denaturation step of 2 min at 94 °C, followed by 36 cycles of 40 s at 94 °C, 45 s at 50 °C, and 1 min at 72 °C, and, in the end, by a final extension step of 5 min at 72 °C. After electrophoresis of the PCR products in agarose gel stained with ethidium bromide, they were purified using the NucleoSpin Gel and PCR Clean-up kit (Macherey-Nagel, Germany) and were sequenced bi-directionally in an ABI-PRISM 3130xl genetic analyzer. Sequences were read, aligned, and phylogenetically resolved using the MEGA 7.0 software [36]. Using the same software, two phylogenetic dendrograms were constructed implementing the maximum likelihood methodology and applying 1000 bootstrap iterations to evaluate the genetic relationships with closely related haplotypes available in GenBank. Furthermore, to explore the disease pathogenesis of the Vibrio identified bacteria, the presence of virulence factors was examined, i.e., vsm and outer membrane protein (ompU) genes in V. splendidus strains and ompU and rtx toxin genes in V. mediterranei strains, using the FastGene Taq 2x Ready Mix with the abovementioned volumes, and primers and conditions as previously described [27,37].
In addition, the potential presence of Mycobacterium sp. and H. pinnae was examined in all tissue samples before bacterial isolation, using the exact same PCR conditions, primers, and procedures as described in Lattos et al. [17].
3. Results
3.1. Molecular Identification of Pathogenic Bacteria
All examined samples were found positive to Mycobacterium sp., whereas only 3 out of the 17 were positive to H. pinnae infection (Table 1). In regard to bacteria cultures, alignment was based on a 950 bp long partial sequence of the 16r RNA gene that defined ten different haplotypes, all belonging to various species of the genus Vibrio (Table 1, Figure 3). In particular, two phylogenetic trees were constructed, the first of which included all new Vibrio haplotypes in comparison to congeneric haplotypes available in the GenBank database (Figure 3a). The haplotype GR139 was identical with V. gigantis strains, whereas the haplotypes GR252 and GR146 were very closely related with V. crassostreae clades. The strains GR131, GR142, and GR147 were phylogenetically very closely related with—and grouped among—V. splendidus haplotypes. Since V. mediterranei was not previously reported in the Aegean Sea and has been characterized as an invasive emerging pathogen, a second tree was also constructed comparing the haplotype GR246 with only V. mediterranei sequences (Figure 3b). Sequence similarity of this haplotype was always more than 98.5%, and up to 100% with V. mediterranei sequences obtained from the GenBank database, and was therefore grouped within V. mediterranei haplotypes. All novel sequences were deposited in the Genbank database under the accession numbers (MW715023–MW715032).

Table 1.
Sampling data of the animals analyzed and the results of microbiological analysis in animal tissues. M, P, G, and GA are the abbreviations for mantle tissue, posterior adductor muscle, gill tissue, and digestive gland, respectively.

Figure 3.
Phylogenetic relationship of the newly described Vibrio haplotypes in comparison with the most closely related ones, obtained from the GenBank database. (a) Maximum likelihood dendrogram including all newly described Vibrio haplotypes in comparison with the most closely related ones. (b) Maximum likelihood dendrogram including only V. mediterranei haplotypes. Haplotype names as in Table 1.
Eventually, to explore the perspective of disease pathogenesis, the presence of virulence factors was investigated in V. splendidus and V. mediterranei infected samples. Five out of the nine V. splendidus strains were positive for both vsm and ompU virulence factor genes, three only for ompU, and one was negative for both virulence factor genes, whereas the V. mediterranei strain was positive for both ompU and rtx virulence factor genes (Table 2).

Table 2.
Presence of virulence factors in V. splendidus and V. mediterranei identified bacteria. Positive samples are indicated with “+” and negative samples are indicated with “-”.
3.2. Antibiograms
All strains were susceptible to the sulfonamide, phenicol, fluoroquinolones, tetracycline, and third generation cephalosporin tested, while they exhibited variable results considering the first-generation cephalosporin, penicillins, macrolide, and aminoglycosides tested. The results are shown in Table 3. There were only 2 strains out of the 17 showing resistance to the first generation cephalosporin or cephalothin, 9 out of the 17 resistant to ampicillin, and 5 to amoxicillin/clavulonate. From the aminoglycoside group, six resistances to neomycin, three to streptomycin and two to kanamycin were recorded. Finally, 2 out of 17 were resistant to erythromycin. All tested strains were susceptible to the sulfonamide, the phenicol, the fluoroquinolones, and the tetracycline. Seven of the strains tested were sensitive to all antibiotics used, while 3 out of the 17 strains tested were the ones with the most resistances encountered. These strains were identified as V. mediterranei and V. crassostreae, all of which originated from Maliakos gulf, Fthiotis and Kalloni gulf, Lesvos island, respectively.

Table 3.
List of the strains and the antibiotics used for the antibiograms (KF: cephalothin, CTX: cefotaxime, AMP: ampicillin, AMC: amoxicillin/clavulonate, K: kanamycin, N: neomycin, GM: gentamycin, S: streptomycin, E: erythromycin, SXT: trimethoprim sulfamethoxazole, FFC: florfenicol, CIP: ciprofloxacin, UB: flumequine, NOR: norfloxacin, TE: tetracycline). The results are depicted by R: resistant and S: susceptible.
3.3. Histological Evaluation of the Inflammatory Responses
Despite the absense of H. pinnae (Figure 4B), specimens infected with V. splendidus showed histopathological lesions to a similar degree as specimens hosting the haplosporidian parasite in the digestive gland (Figure 4A). In the same way, heavy inflammatory responses were observed in all specimens, whether or not the H. pinnae was present. Diffuse type inflammation was observed in all specimens.

Figure 4.
Histological display of the digestive gland of two different P. nobilis specimens. (A) Digestive gland of fan mussel infected with Mycobacterium sp., H. pinnae, and V. splendidus. (B) Digestive gland of fan mussel infected only with Mycobacterium sp. and V. splendidus. Both exhibit heavy inflammation responses and heavy lesions in the connective tissue of the digestive gland. A degenerative process was also indicated in the epithelium of the digestive tubules of both specimens, regardless of the presence of H. pinnae.
4. Discussion
4.1. Molecular Characterization of Vibrio Species
The strain GR246, found in Maliakos gulf, was grouped within V. mediterranei clade strains (Figure 3b), providing evidence for its identification as V. mediterranei. V. shilloni, which was also very closely phylogenetically related with this group, is a coral pathogen [38,39], whereas V. mediterranei is a pathogen of bivalves that was recently found infecting P. nobilis as well. Keeping this in mind, we can propose that the derived Vibrio haplotype in the specimens originating from Maliakos gulf belongs to the species V. mediterranei. To the best of our knowledge, this is the first report of V. mediterranei in the Aegean Sea isolated from P. nobilis.
At least three different Vibrio haplotypes were clustered within the V. splendidus group. Specifically, haplotype GR139 was identical to several V. splendidus, V. gigantis, and V. crassostreae strains, while haplotypes GR252 and GR146 represent newly described sequences, more closely phylogenetically related to V. chagasi than to V. splendidus and V. crassostreae. Although, in this case, the phylogeny is too complicated to extract safe conclusions regarding the molecular taxonomy of this strain; based on the life history and geographic distribution of each species, we can postulate that it is probably V. splendidus. Notably, this is also the first report of V. splendidus hosting P. nobilis in the Greek seas.
Furthermore, the isolate GR247 detected with P. nobilis specimens from Kalloni gulf, Lesvos island was genetically close within the same clade, and particularly in the same branch as V. toranzoniae. This species was first described in 2013, hosting healthy reared individuals of the clams Venerupis philippinarum and Venerupis decussata originating from Galicia, Spain [40].
Finally, two different isolates, phylogenetically very closely related, were grouped within the V. harveyi group. Both isolates represent novel haplotypes. Despite the fact that, similarly to the case of V. splendidus clade, no safe conclusions can be considered regarding their molecular identification; it should be pointed that these strains were genetically distinct from all the remaining ones.
4.2. Microbiological Characterisation of Vibrio Species and Susceptibility in Antibiotics
As far as the antibiograms that were conducted in this study are concerned, we did not record important resistances in the strains tested. Antimicrobial resistance among halophilic Vibrio species isolated from oysters, mussels, and clams was studied in Canada for 6 years and reported that only 4.9% of the strains used were sensitive to all drugs tested, while in our study, fewer resistances were reported [41]. According to the same authors, similar antimicrobial resistance patterns to ours were detected reporting ampicillin, cephalothin, erythromycin, kanamycin, and streptomycin to be the antibiotics with the higher recorded resistances. Additionally, it has been reported that more than 90% of the Vibrio isolates tested showed resistance to streptomycin, whereas many strains (50%) were resistant to penicillin, carbenicillin, ampicillin, cephalothin, and kanamycin [42]. Τhese resistances are attributed to the environmental pressure posed by various human activities [41].
The antibiotic profile of the strains was conducted not only for a possible selection of a drug to be used in order to treat an infection, but also represents a marker of the dominant spatial environmental conditions, considering the antibiotic resistance genes that are exchanged between the most dominant bacteria, such as bacteria belonging to the Vibrio species.
It is interesting to note that, for the Ampicillin, there is a significant difference between the two populations. However, this is at the limits of Bonferroni correction. Additionally, there is a valid statistical difference between the two sites regarding the resistance to antibiotics in general, with the bacteria detected in fan mussels originating from Kalloni being more resistant to antibiotics (p: 0.000, G-test: 185.5, df = 3). This is of particular importance on account of the continuous efforts to detect healthy fan mussel populations to be used in regeneration attempts.
4.3. Potential Impacts on Mortalities
Coastal and estuarine environments constitute marine mollusk habitat areas, which, due to their filter-feeding behavior, accumulate a large amount of bacterial microbiota [43]. In the marine environment, bivalve mollusks constitute habitats for the Vibrionaceae family and for other bacterial species [8]. To date, 142 species have been reported within the Vibrionaceae family, classified in seven genera, with the genus Vibrio representing the most variable one [44,45]. However, members of the genus Vibrio have been described and characterized as causative agents for many mass mortality episodes worldwide, affecting all the life stages of bivalves [43]. Bacteria have formed symbiotic relationships with their hosts, benefiting them in digestion, in nutrient absorption, in defense mechanisms against infectious pathogens, and in the formation of reproduction strategies. Conversely, the host provides a stable environment with a constant supply of nutrients for the symbiotic bacteria [46,47,48]. Some of them are also vital for natural systems, including the carbon cycle and osmoregulation [49]. There is a wide diversity of pathogenic bacteria belonging to the genus Vibrio associated with mass mortalities in marine bivalve mollusks [50]. Among the pathogenic Vibrio spp., vibrios belonging to the splendidus clade have been described many times as causative agents of pathogenicities in marine organisms, and, in particular, to bivalves. V. splendidus has been reported worldwide hosted by the Pacific oyster, Crassostrea gigas, causing mortalities of up to 100% of the infected population in several cases [10,51,52,53,54]. However, V. splendidus clade bacteria have a wide range of bivalve mollusk hosts, such as scallops, mussels, and clams, causing similar harmful effects as in oysters [55,56,57,58,59,60]. Vibriosis in bivalve mollusks, caused by bacteria belonging to the splendidus clade, is associated with histopathological lesions, such as the disorganization of muscle fibers and strong inflammatory responses, as well as the general depression of the physiology [56,61]. Another pathogenic agent, belonging to Vibrionaceae family, causing mortalities in a wide variety of aquatic animals is V. harveyi, although it has been shown to belong to the microbiome of most of the infected hosts [62]. V. harveyi strains have been detected in many hosts such as crabs, teleosts, crustaceans, and bivalve mollusks, causing immune and physiological depression and mortalities [63,64,65,66,67,68]. V. mediterranei is considered to be an emerging pathogen, being abundant in aquatic environments, infecting hosts such as corals and seaweeds and causing mortalities synergistically with other pathogens [69,70]. This Vibrio species was from plankton, sediments, and seawater samples from two coastal areas in south Valencia, Spain [71].
Concerning the mortalities in fan mussel populations in the Mediterranean Sea, two potential pathogens were firstly identified as the etiological agents causing the mortalities. These pathogens were H. pinnae and Mycobacterium sp.; many other potential pathogens were also detected in samples originating from areas where mortalities occurred, making it more difficult to fully understand the phenomenon of these extended declines in the populations of the species. Nevertheless, recent studies, both in the field and in laboratory conditions, involve the presence of Vibrio species among the pathogens of fan mussel populations. Particularly Vibrio spp. of the Splendidus clade and V. mediterranei were detected in a field study and in laboratory conditions, respectively, hosting the fan mussel [26,28]. The current study demonstrated the existence of Vibrio bacterial strains in moribund samples of P. nobilis, originated from Maliakos gulf, Fthiotis and Kalloni gulf, Lesvos island, the last two surviving populations across the Greek coastline. Analysis of the low-scale winter mortalities demonstrated differential patterns of pathogen abundance among the specimens collected from the mortality events that took place in 2020 in the Greek coastal areas. H. pinnae abundance was limited, present only in three samples from the total of thirty collected, assuming that its spread is probably restricted by the lower temperatures. All specimens infected by the haplosporidian parasite originated from Maliakos gulf, Fthiotis. On the other hand, mycobacteriosis continued to exist in all fan mussel specimens in a 100% ratio in both examined areas.
Concerning the histopathological results, no correlation can be observed with the presence of Vibrio spp., and this can be attributed to the complexity of the mortalities in fan mussels. P. nobilis populations face a multi-pathogen situation alongside the direct and indirect human pressures. Prevalence of mycobacteriosis is 100% in all populations investigated across the Greek coastline during the last three years. With the presence of this chronic disease, P. nobilis populations are affected by a chronic stress resulting in a general vulnerability to diseases.
According to our results, low-temperature mortalities may be attributed to many potential pathogens, acting as causative agents for the reduction of the natural populations, even in the winter. V. splendidus strains, which were abundant in the majority of the examined specimens, have been reported to exhibit their highest virulence at low temperatures, especially considering the presence of virulence genes, while their pathogenicity is reduced at increased temperatures [58,72]. Virulence genes upregulate the transmission and the reproduction rate of the pathogen [27]. The presence of virulence genes, particularly in V. splendidus and V. mediterranei, support the scenario of pathogenicity of vibrios in the Aegean Sea, as well as their contribution in winter mortalities. Our results therefore provide evidence that the devastation of the population of the fan mussel is far from clear, suggesting that many microorganisms may be implicated in this phenomenon. More epidemiological studies are needed, particularly from unaffected populations, to enlighten these phenomena. The Sea of Marmara was recently determined as such an area where healthy P. nobilis individuals, free of parasites, were detected [24]. Presumably, the outflow from the Dardanelles towards the Aegean Sea, forming a physical gene flow barrier from the Mediterranean in the direction of the Sea of Marmara [73], still prevents the expansion of the P. nobilis pathogens in this direction. Considering the harmful effects of climate change in combination with human pressure, despite the legal restrictions (illegal fishing, destruction of habitats), an action plan is considered as an emergency measure to prevent the extinction of the species, taking into account unaffected populations.
Author Contributions
Conceptualization, A.L., K.B. and I.A.G.; methodology, A.L., K.B. and I.A.G.; software, A.L.; validation, J.A.T., C.B. and B.M.; investigation A.L., K.B. and I.A.G.; resources, A.L., K.B. and I.A.G.; writing—original draft preparation, A.L.; writing—review and editing, A.L., K.B. and I.A.G.; supervision, J.A.T., C.B. and B.M.; project administration, A.L., K.B. and I.A.G.; funding acquisition, A.L., K.B., I.A.G. and J.A.T. All authors have read and agreed to the published version of the manuscript.
Funding
This research is a part of the project “Innovative Actions For The Monitoring-Recovering –Enhancement of The Natural Recruitment of The Endangered Species (Fan mussel) Pinna nobilis, that was funded by the Operational Program for Fisheries and Maritime 2014–2020 (Measure 6.1.16” Innovation Linked to the Conservation of Marine Biological Resources”), grant number (MIS) 5052394” This action was co-funded by the European Maritime and Fisheries Fund (EMFF).
Institutional Review Board Statement
Ethical review and approval were waived for this study, due to a license received from the Greek Ministry of Environment and Energy (code: MEE//GDDDP89926/1117).
Informed Consent Statement
Not applicable.
Data Availability Statement
Data is contained within the article.
Conflicts of Interest
The authors declare no conflict of interest.
References
- Casillo, A.; Lanzetta, R.; Parrilli, M.; Corsaro, M.M. Exopolysaccharides from marine and marine extremophilic bacteria: Structures, properties, ecological roles and applications. Mar. Drugs 2018, 16, 69. [Google Scholar] [CrossRef] [PubMed]
- Mcfall-ngai, M.J. Unseen Forces: The Influence of Bacteria on Animal Development. Dev. Biol. 2002, 242, 1–14. [Google Scholar] [CrossRef] [PubMed]
- Offret, C.; Rochard, V.; Laguerre, H.; Mounier, J.; Huchette, S.; Brillet, B.; Le Chevalier, P.; Fleury, Y. Protective Efficacy of a Pseudoalteromonas Strain in European Abalone, Haliotis tuberculata, Infected with Vibrio harveyi ORM4. Probiotics Antimicro. Prot. 2019, 11, 239–247. [Google Scholar] [CrossRef] [PubMed]
- Offret, C.; Paulino, S.; Gauthier, O.; Ch, K.; Bidault, A.; Corporeau, C.; Miner, P.; Petton, B.; Pernet, F.; Fabioux, C.; et al. The marine intertidal zone shapes oyster and clam digestive bacterial microbiota. FEMS Microbiol. Ecol. 2020, 96, 1–12. [Google Scholar] [CrossRef] [PubMed]
- Garnier, M.; Labreuche, Y.; Garcia, C.; Robert, M.; Nicolas, J.L. Evidence for the involvement of pathogenic bacteria in summer mortalities of the pacific oyster Crassostrea Gigas. Microb. Ecol. 2007, 53, 187–196. [Google Scholar] [CrossRef] [PubMed]
- Husmann, G.; Philipp, E.E.R.; Rosenstiel, P.; Vazquez, S.; Abele, D. Immune response of the Antarctic bivalve Laternula elliptica to physical stress and microbial exposure. J. Exp. Mar. Bio. Ecol. 2011, 398, 83–90. [Google Scholar] [CrossRef]
- Matozzo, V.; Marin, M.G. Bivalve immune responses and climate changes: Is there a relationship? Invertebr. Surviv. J. 2011, 8, 70–77. [Google Scholar]
- Destoumieux-garzón, D.; Canesi, L.; Oyanedel, D.; Travers, M.; Charrière, G.M.; Pruzzo, C.; Vezzulli, L. Vibrio—bivalve interactions in health and disease. Environ. Microbiol. 2020, 22, 4323–4341. [Google Scholar] [CrossRef] [PubMed]
- Paul-pont, I.; Montaudouin, X.D.; Gonzalez, P.; Jude, F.; Raymond, N.; Paillard, C.; Baudrimont, M. Interactive effects of metal contamination and pathogenic organisms on the introduced marine bivalve Ruditapes philippinarum in European populations. Environ. Pollut. 2010, 158, 3401–3410. [Google Scholar] [CrossRef]
- Saulnier, D.; de Decker, S.; Haffner, P.; Cobret, L.; Robert, M.; Garcia, C. A large-scale epidemiological study to identify bacteria pathogenic to Pacific Oyster Crassostrea gigas and correlation between virulence and metalloprotease-like activity. Microb. Ecol. 2010, 59, 787–798. [Google Scholar] [CrossRef]
- Darriba, S. First haplosporidan parasite reported infecting a member of the Superfamily Pinnoidea (Pinna nobilis) during a mortality event in Alicante (Spain, Western Mediterranean). J. Invertebr. Pathol. 2017, 148, 14–19. [Google Scholar] [CrossRef] [PubMed]
- Vázquez-Luis, M.; Álvarez, E.; Barrajón, A.; García-March, J.R.; Grau, A.; Hendriks, I.E.; Jiménez, S.; Kersting, D.; Moreno, D.; Pérez, M.; et al. SOS Pinna nobilis: A mass mortality event in western Mediterranean Sea. Front. Mar. Sci. 2017, 4, 1–6. [Google Scholar] [CrossRef]
- Catanese, G.; Grau, A.; Valencia, J.M.; Garcia-March, J.R.; Vázquez-Luis, M.; Alvarez, E.; Deudero, S.; Darriba, S.; Carballal, M.J.; Villalba, A. Haplosporidium pinnae sp. nov., a haplosporidan parasite associated with mass mortalities of the fan mussel, Pinna nobilis, in the Western Mediterranean Sea. J. Invertebr. Pathol. 2018, 157, 9–24. [Google Scholar] [CrossRef]
- Carella, F.; Aceto, S.; Pollaro, F.; Miccio, A.; Iaria, C.; Carrasco, N.; Prado, P.; De Vico, G. A mycobacterial disease is associated with the silent mass mortality of the pen shell Pinna nobilis along the Tyrrhenian coastline of Italy. Sci. Rep. 2019, 9, 1–12. [Google Scholar] [CrossRef]
- Panarese, R.; Tedesco, P.; Chimienti, G.; Latrofa, M.S.; Quaglio, F.; Passantino, G.; Buonavoglia, C.; Gustinelli, A.; Tursi, A.; Otranto, D. Haplosporidium pinnae associated with mass mortality in endangered Pinna nobilis (Linnaeus 1758) fan mussels. J. Invertebr. Pathol. 2019, 164, 32–37. [Google Scholar] [CrossRef]
- Katsanevakis, S. The cryptogenic parasite Haplosporidium pinnae invades the Aegean Sea and causes the collapse of Pinna nobilis populations. Aquat. Invasions 2019, 14, 150–164. [Google Scholar] [CrossRef]
- Lattos, A.; Giantsis, I.A.; Karagiannis, D.; Michaelidis, B. First detection of the invasive Haplosporidian and Mycobacteria parasites hosting the endangered bivalve Pinna nobilis in Thermaikos Gulf, North Greece. Mar. Environ. Res. 2020, 155, 104889. [Google Scholar] [CrossRef] [PubMed]
- Kersting, D.; Benabdi, M.; Čižmek, H.; Grau, A.; Jimenez, C.; Katsanevakis, S.; Öztürk, B.; Tuncer, S.; Tunesi, L.; Vázquez-Luis, M.; et al. Pinna nobilis, Fan Mussel. IUCN Red List Threat. Species 2019, 2019, e.T160075998A160081499. [Google Scholar] [CrossRef]
- Zotou, M.; Gkrantounis, P.; Karadimou, E.; Tsirintanis, K.; Sini, M.; Poursanidis, D.; Azzolin, M.; Dailianis, T.; Kytinou, E.; Issaris, Y.; et al. Pinna nobilis in the Greek seas (NE Mediterranean): On the brink of extinction? Mediterr. Mar. Sci. 2020, 21, 575–591. [Google Scholar] [CrossRef]
- Öndes, F.; Alan, V.; Akçalı, B.; Güçlüsoy, H. Mass mortality of the fan mussel, Pinna nobilis in Turkey (eastern Mediterranean). Mar. Ecol. 2020, 41, 1–5. [Google Scholar] [CrossRef]
- Özalp, H.B.; Kersting, D.K. A pan-Mediterranean extinction? Pinna nobilis mass mortality has reached the Turkish straits system. Mar. Biodivers. 2020, 50, 81. [Google Scholar] [CrossRef]
- Hrvoje, Č.; Barbara, Č.; Gra, R.; Grau, A.; Catanese, G. An emergency situation for pen shells in the Mediterranean: The Adriatic Sea, one of the last Pinna nobilis shelters, is now affected by a mass mortality event. J. Invertebr. Pathol. 2020, 173, 1–5. [Google Scholar] [CrossRef]
- Šarić, T.; Župan, I.; Aceto, S.; Villari, G.; Palić, D.; De Vico, G.; Carella, F. Epidemiology of noble pen shell (Pinna nobilis l. 1758) mass mortality events in adriatic sea is characterised with rapid spreading and acute disease progression. Pathogens 2020, 9, 776. [Google Scholar] [CrossRef]
- Cinar, M.; Bilecenoglu, M.; Yokes, M.; Guclusoy, H. Pinna nobilis in the south Marmara Islands (Sea of Marmara); it still remains uninfected by the epidemic and acts as egg laying substratum for an alien invader. Mediterr. Mar. Sci. 2021, 22, 161–168. [Google Scholar] [CrossRef]
- Carella, F.; Antuofermo, E.; Farina, S.; Salati, F.; Mandas, D.; Prado, P.; Panarese, R.; Marino, F.; Fiocchi, E.; Pretto, T.; et al. In the Wake of the Ongoing Mass Mortality Events: Co-occurrence of Mycobacterium, Haplosporidium and Other Pathogens in Pinna nobilis Collected in Italy and Spain (Mediterranean Sea). Front. Mar. Sci. 2020, 7, 48. [Google Scholar] [CrossRef]
- Prado, P.; Carrasco, N.; Catanese, G.; Grau, A.; Cabanes, P.; Carella, F.; García-March, J.R.; Tena, J.; Roque, A.; Bertomeu, E.; et al. Presence of Vibrio mediterranei associated to major mortality in stabled individuals of Pinna nobilis L. Aquaculture 2020, 519, 734899. [Google Scholar] [CrossRef]
- Andree, K.B.; Carrasco, N.; Carella, F.; Furones, D.; Prado, P. Vibrio mediterranei, a potential emerging pathogen of marine fauna: Investigation of pathogenicity using a bacterial challenge in Pinna nobilis and development of a species-specific PCR. J. Appl. Microbiol. 2020, 130, 617–631. [Google Scholar] [CrossRef]
- Pavlinec, Ž.; Zupičić, I.G.; Oraić, D.; Petani, B.; Mustać, B.; Mihaljević, Ž.; Beck, R.; Zrnčić, S. Assessment of predominant bacteria in noble pen shell (Pinna nobilis) collected in the Eastern Adriatic Sea. Environ. Monit. Assess. 2020, 192, 581. [Google Scholar] [CrossRef]
- Scarpa, F.; Sanna, D.; Azzena, I.; Mugetti, D.; Cerruti, F.; Hosseini, S.; Cossu, P.; Pinna, S.; Grech, D.; Cabana, D.; et al. Multiple non-species-specific pathogens possibly triggered the mass mortality in Pinna nobilis. Life 2020, 10, 238. [Google Scholar] [CrossRef] [PubMed]
- Box, A.; Capó, X.; Tejada, S.; Catanese, G.; Grau, A.; Deudero, S.; Sureda, A.; Valencia, J.M. Reduced antioxidant response of the fan mussel Pinna nobilis related to the presence of haplosporidium pinnae. Pathogens 2020, 9, 932. [Google Scholar] [CrossRef]
- Lattos, A.; Giantsis, I.A.; Karagiannis, D.; Theodorou, J.A.; Michaelidis, B. Gut Symbiotic Microbial Communities in the IUCN Critically Endangered Pinna nobilis Suffering from Mass Mortalities, Revealed by 16S rRNA Amplicon NGS. Pathogens 2020, 9, 1002. [Google Scholar] [CrossRef]
- Rabaoui, L.; Tlig-Zouari, S.; Katsanevakis, S.; Ben Hassine, O.K. Modelling population density of Pinna nobilis (Bivalvia) on the eastern and southeastern coast of Tunisia. J. Molluscan Stud. 2010, 76, 340–347. [Google Scholar] [CrossRef]
- Vázquez-Luis, M.; Borg, J.A.; Morell, C.; Banach-Esteve, G.; Deudero, S. Influence of boat anchoring on Pinna nobilis: A field experiment using mimic units. Mar. Freshw. Res. 2015, 66, 786–794. [Google Scholar] [CrossRef]
- Weinstein, M.P.; Patel, J.B.; Burnhman, C.-A.; ZImmer, B.L. Clinical and Laboratory Standards Institute Methods for Dilution Antimicrobial Susceptibility Tests for Bacteria That Grow Aerobically Standard, Approval CDM-A. M07 Methods Dilution Antimicrob. Susceptibility Tests Bact. Grow Aerob. 2018, 91. Available online: https://kaldur.landspitali.is/focal/gaedahandbaekur/gnhsykla.nsf/5e27f2e5a88c898e00256500003c98c2/4c17737f339875620025756e003852bb/$FILE/M07Ed11E%20Methods%20for%20Dilution%20Antimicrobial%20Susceptibility%20Tests%20for%20Bacteria%20That%20Grow%20Aerobically.pdf (accessed on 1 April 2021).
- Frank, J.A.; Reich, C.I.; Sharma, S.; Weisbaum, J.S.; Wilson, B.A.; Olsen, G.J. Critical evaluation of two primers commonly used for amplification of bacterial 16S rRNA genes. Appl. Environ. Microbiol. 2008, 74, 2461–2470. [Google Scholar] [CrossRef] [PubMed]
- Kumar, S.; Stecher, G.; Tamura, K. MEGA7: Molecular Evolutionary Genetics Analysis Version 7.0 for Bigger Datasets. Mol. Biol. Evol. 2016, 33, 1870–1874. [Google Scholar] [CrossRef] [PubMed]
- Nasfi, H.; Travers, M.A.; de Lorgeril, J.; Habib, C.; Sannie, T.; Sorieul, L.; Gerard, J.; Avarre, J.C.; Haffner, P.; Tourbiez, D.; et al. A European epidemiological survey of Vibrio splendidus clade shows unexplored diversity and massive exchange of virulence factors. World J. Microbiol. Biotechnol. 2015, 31, 461–475. [Google Scholar] [CrossRef] [PubMed]
- Ben-haim, Y.; Banim, E.; Kushmaro, A. Inhibition of photosynthesis and bleaching of zooxanthellae by the coral pathogen Vibrio shiloi. Environ. Microbiol. 1999, 1, 223–229. [Google Scholar] [CrossRef] [PubMed]
- Banin, E.; Khare, S.K.; Naider, F.; Rosenberg, E. Proline-Rich Peptide from the Coral Pathogen Vibrio shiloi That Inhibits Photosynthesis of Zooxanthellae. Appl. Environ. Microbiol. 2001, 67, 1536–1541. [Google Scholar] [CrossRef] [PubMed]
- Lasa, A.; Diéguez, A.L.; Romalde, J.L. Vibrio toranzoniae sp. nov., a new member of the Splendidus clade in the genus Vibrio. Syst. Appl. Microbiol. 2013, 36, 96–100. [Google Scholar] [CrossRef]
- Banerjee, S.K.; Farber, J.M. Trend and pattern of antimicrobial resistance in molluscan Vibrio species sourced to Canadian estuaries. bioRxiv 2018, 62, 1–9. [Google Scholar] [CrossRef]
- Ottaviani, D.; Bacchiocchi, I.; Masini, L.; Leoni, F.; Carraturo, A.; Giammarioli, M.; Sbaraglia, G. Antimicrobial susceptibility of potentially pathogenic halophilic vibrios isolated from seafood. Int. J. Antimicrob. Agents 2001, 18, 135–140. [Google Scholar] [CrossRef]
- Beaz-Hidalgo, R.; Balboa, S.; Romalde, J.L.; Figueras, M.J. Diversity and pathogenecity of Vibrio species in cultured bivalve molluscs. Environ. Microbiol. Rep. 2010, 2, 34–43. [Google Scholar] [CrossRef]
- Sawabe, T.; Ogura, Y.; Matsumura, Y.; Feng, G.; Rohul Amin, A.K.M.; Mino, S.; Nakagawa, S.; Sawabe, T.; Kumar, R.; Fukui, Y.; et al. Updating the Vibrio clades defined by multilocus sequence phylogeny: Proposal of eight new clades, and the description of Vibrio tritonius sp. nov. Front. Microbiol. 2013, 4, 414. [Google Scholar] [CrossRef]
- Prado, S.; Dubert, J.; Barja, J.L. Characterization of pathogenic vibrios isolated from bivalve hatcheries in Galicia, NW Atlantic coast of Spain. Description of Vibrio tubiashii subsp. europaensis subsp. nov. Syst. Appl. Microbiol. 2015, 38, 26–29. [Google Scholar] [CrossRef]
- Pierce, M.L.; Ward, J.E. Microbial Ecology of the Bivalvia, with an Emphasis on the Family Ostreidae Microbial Ecology of the Bivalvia, with an Emphasis on the Family Ostreidae. J. Shellfish Res. 2018, 37, 793–806. [Google Scholar] [CrossRef]
- Bernasconi, R.; Stat, M.; Koenders, A.; Paparini, A.; Bunce, M.; Huggett, M.J.; Meyer, J.L. Establishment of Coral-Bacteria Symbioses Reveal Changes in the Core Bacterial Community With Host Ontogeny. Front. Microbiol. 2019, 10, 1529. [Google Scholar] [CrossRef] [PubMed]
- Dishaw, L.J.; Cannon, J.P.; Litman, G.W.; Parker, W. Immune-directed support of rich microbial communities in the gut has ancient roots. Dev. Comp. Immunol. 2014, 47, 36–51. [Google Scholar] [CrossRef] [PubMed]
- Johnson, C.N. Fitness Factors in Vibrios: A Mini-review. Microb. Ecol. 2013, 65, 826–851. [Google Scholar] [CrossRef]
- Romalde, J.L.; Diéguez, A.L.; Lasa, A.; Balboa, S. New Vibrio species associated to molluscan microbiota: A review. Front. Microbiol. 2014, 4, 413. [Google Scholar] [CrossRef]
- Sugumar, G.; Nakai, T.; Hirata, Y.; Matsubara, D.; Muroga, K. Vibrio splendidus biovar II as the causative agent of bacillary necrosis of Japanese oyster Crassostrea gigas larvae. Dis. Aquat. Organ. 1998, 33, 111–118. [Google Scholar] [CrossRef]
- Lacoste, A.; Jalabert, F.; Malham, S.; Cueff, A.; Gélébart, F.; Cordevant, C.; Lange, M.; Poulet, S.A. A Vibrio splendidus strain is associated with summer mortality of juvenile oysters Crassostrea gigas in the Bay of Morlaix (North Brittany, France). Dis. Aquat. Organ. 2001, 46, 139–145. [Google Scholar] [CrossRef]
- Le Roux, F.; Gay, M.; Lambert, C.; Waechter, M.; Poubalanne, S.; Chollet, B.; Nicolas, J.L.; Berthe, F. Comparative analysis of Vibrio splendidus-related strains isolated during Crassostrea gigas mortality events. Aquat. Living Resour. 2002, 15, 251–258. [Google Scholar] [CrossRef]
- Gay, M.; Renault, T.; Pons, A.M.; Le Roux, F. Two Vibrio splendidus related strains collaborate to kill Crassostrea gigas: Taxonomy and host alterations. Dis. Aquat. Organ. 2004, 62, 65–74. [Google Scholar] [CrossRef]
- Nicolas, J.L.; Corre, S.; Gauthier, G.; Robert, R.; Ansquer, D. Bacterial problems associated with scallop Pecten maximus larval culture. Dis. Aquat. Org. 1996, 27, 67–76. [Google Scholar] [CrossRef]
- Gomez-Leon, J.; Villamil, L.; Lemos, M.L.; Novoa, B.; Figueras, A. Isolation of Vibrio alginolyticus and Vibrio splendidus from Aquacultured Carpet Shell Clam (Ruditapes decussatus) Larvae Associated with Mass Mortalities. Appl. Environ. Microbiol. 2005, 71, 98–104. [Google Scholar] [CrossRef]
- Kesarcodi-Watchon, A.; Kaspar, H.; Lategan, M.J.; Gibson, L. Two pathogens of Greenshell mussel larvae, Perna canaliculus: Vibrio splendidus and a V. coralliilyticus/neptunius-like isolate. J. Fish Dis. 2009, 32, 499–507. [Google Scholar] [CrossRef]
- Liu, R.; Qiu, L.; Yu, Z.; Zi, J.; Yue, F.; Wang, L.; Zhang, H.; Teng, W.; Liu, X.; Song, L. Identification and characterisation of pathogenic Vibrio splendidus from Yesso scallop (Patinopecten yessoensis) cultured in a low temperature environment. J. Invertebr. Pathol. 2013, 114, 144–150. [Google Scholar] [CrossRef]
- Rojas, R.; Miranda, C.D.; Opazo, R.; Romero, J. Characterization and pathogenicity of Vibrio splendidus strains associated with massive mortalities of commercial hatchery-reared larvae of scallop Argopecten purpuratus (Lamarck, 1819). J. Invertebr. Pathol. 2015, 124, 61–69. [Google Scholar] [CrossRef] [PubMed]
- Oden, E.; Burioli, E.A.V.; Trancart, S.; Pitel, P.H.; Houssin, M. Multilocus sequence analysis of Vibrio splendidus related-strains isolated from blue mussel Mytilus sp. during mortality events. Aquaculture 2016, 464, 420–427. [Google Scholar] [CrossRef]
- Parisi, M.G.; Maisano, M.; Cappello, T.; Oliva, S.; Mauceri, A.; Toubiana, M.; Gammarata, M. Responses of marine mussel Mytilus galloprovincialis (Bivalvia: Mytilidae) after infection with the pathogen Vibrio splendidus. Comp. Biochem. Physiol. Part C 2019, 221, 1–9. [Google Scholar] [CrossRef]
- Zhang, X.; Bai, X.; Yan, B.; Bi, K.; Qin, L. Vibrio harveyi as a causative agent of mass mortalities of megalopa in the seed production of swimming crab Portunus trituberculatus. Aquacult. Int. 2014, 22, 661–672. [Google Scholar] [CrossRef]
- Alabi, A.O.; Jones, D.A.; Latchford, J.W. The efficacy of immersion as opposed to oral vaccination of Penaeus indicus larvae against Vibrio harveyi. Aquaculture 1999, 178, 1–11. [Google Scholar] [CrossRef]
- Hashem, M.; El-barbary, M. Vibrio harveyi infection in Arabian Surgeon fish (Acanthurus sohal) of Red Sea at Hurghada, Egypt. Egypt. J. Aquat. Res. 2013, 39, 199–203. [Google Scholar] [CrossRef]
- Firmino, J.; Furones, M.D.; Andree, K.B.; Sarasquete, C.; Ortiz-Delgado, J.B.; Asencio-Alcudia, G.; Gisbert, E. Contrasting outcomes of Vibrio harveyi pathogenicity in gilthead seabream, Sparus aurata and European seabass, Dicentrachus labrax. Aquaculture 2019, 511, 734210. [Google Scholar] [CrossRef]
- Wei, Z.; Xin, L.; Zhang, W.; Bai, C.; Wang, C. Isolation and characterization of Vibrio harveyi as a major pathogen associated with mass mortalities of ark clam, Scapharca broughtonii, in summer. Aquaculture 2019, 511, 734248. [Google Scholar] [CrossRef]
- Liu, X.; Ji, C.; Zhao, J.; Wang, Q.; Li, F.; Wu, H. Metabolic profiling of the tissue-specific responses in mussel Mytilus galloprovincialis towards Vibrio harveyi challenge. Fish Shellfish Immunol. 2014, 39, 372–377. [Google Scholar] [CrossRef]
- Deepika, A.; Sreedharan, K.; Rajendran, K.V. Responses of some innate immune-genes involved in the toll-pathway in black tiger shrimp (Penaeus monodon) to Vibrio harveyi infection and on exposure to ligands in vitro. J. World Aquac. Soc. 2020, 51, 1419–1429. [Google Scholar] [CrossRef]
- Thompson, F.L.; Hoste, B.; Thompson, C.C.; Huys, G.; Swings, J. The coral bleaching Vibrio shiloi Kushmaro et al. 2001 is a later synonym of Vibrio mediterranei Pujalte and Garay 1986. Syst. Appl. Microbiol. 2001, 24, 516–519. [Google Scholar] [CrossRef] [PubMed]
- Yang, R.; Liu, Q.; He, Y.; Tao, Z.; Xu, M.; Luo, Q.; Chen, J. Isolation and identification of Vibrio mediterranei 117-T6 as a pathogen associated with yellow spot disease of Pyropia (Bangiales, Rhodophyta). Aquaculture 2020, 526, 735372. [Google Scholar] [CrossRef]
- Pujalte, M.J.; Garay, E. Proposal of Vibrio mediterranei sp. nov.: A New Marine Member of the Genus Vibrio. Int. J. Syst. Bact. 1986, 36, 278–281. [Google Scholar] [CrossRef]
- Liu, R.; Chen, H.; Zhang, R.; Zhou, Z.; Hou, Z.; Gao, D.; Zhang, H.; Wang, L.; Song, L. Comparative transcriptome analysis of Vibrio splendidus JZ6 reveals the mechanism of its pathogenicity at low temperatures. Appl. Environ. Microbiol. 2016, 82, 2050–2061. [Google Scholar] [CrossRef] [PubMed]
- Giantsis, I.A.; Mucci, N.; Randi, E.; Abatzopoulos, T.J.; Apostolidis, A.P. Microsatellite variation of mussels (Mytilus galloprovincialis) in central and eastern Mediterranean: Genetic panmixia in the Aegean and the Ionian Seas. J. Mar. Biol. Assoc. UK 2014, 94, 797–809. [Google Scholar] [CrossRef]
Publisher’s Note: MDPI stays neutral with regard to jurisdictional claims in published maps and institutional affiliations. |
© 2021 by the authors. Licensee MDPI, Basel, Switzerland. This article is an open access article distributed under the terms and conditions of the Creative Commons Attribution (CC BY) license (https://creativecommons.org/licenses/by/4.0/).